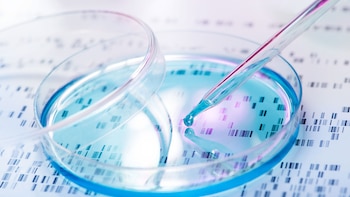
La biología molecular sigue los

En la serie televisiva The Last of Us, un hongo desencadena una pandemia mundial y convierte a sus víctimas en atacantes sedientos de sangre. Un grupo de investigadores de la Universidad de Duke, en los Estados Unidos, afirmaron que la amenaza por hongos es un escenario plausible en el futuro. Si bien los seres humanos no se volverían “zombies”, existe la posibilidad de que una especie de hongo sufra mutaciones como consecuencias de la crisis climática.
En diálogo con Infobae, una de las autoras de la investigación, la científica Asiya Gusa, contó: “Ya estamos viendo un aumento en las infecciones invasivas por hongos, pero todavía estamos investigando las causas. Veremos más infecciones por hongos y enfermedades en humanos en el futuro, como resultado del aumento de las poblaciones con sistemas inmunológicos debilitados y una mayor dispersión de esporas de hongos en el ambiente por el cambio climático”.
Si bien aún no tenemos evidencia directa que asocie al estrés por calor con un aumento de las enfermedades fúngicas, la investigadora dijo que “es probable que el aumento de las temperaturas haga que los hongos se adapten para tolerar mejor el calor, y sabemos que solo los hongos que sobreviven a la temperatura del cuerpo humano pueden causar enfermedades”.
Si el estrés por calor actúa como un desencadenante en los hongos para que aumenten su tasa de mutación “es probable que la adaptación ocurra más rápido. Nuevamente, se necesita más investigación, herramientas de diagnóstico y vigilancia de hongos en el ambiente y en infecciones humanas”, afirmó la doctora Gusa.

Hasta ahora las bacterias y los virus son han atraído más la atención por su rol en el desarrollo de pandemias mortales e infecciones molestas. Pero los patógenos como los hongos también están ganando terreno. Los hongos como Candida, Aspergillus, Cryptococcus y otros pueden afectar más a personas inmunodeprimidas.
Los científicos de la Facultad de Medicina de la Universidad de Duke publicaron un estudio en el que revelaron que el aumento de las temperaturas provoca que un hongo patógeno conocido como Cryptococcus deneoformans active sus respuestas adaptativas.
Eso significa que ese hongo aumenta su número de cambios genéticos, algunos de los cuales podrían presumiblemente conducir a una mayor resistencia al calor, y otros tal vez hacia un mayor potencial causante de enfermedades.

El aumento del calor hace que más elementos móviles del ADN del hongo se levanten y se muevan y provocan cambios en la forma en que se utilizan y regulan sus genes. Los resultados de la investigación fueron publicados en la revista Proceedings of the National Academy of Sciences (PNAS).
Según Gusa, del área de Genética Molecular y Microbiología en la Facultad de Medicina de Duke, el estrés térmico puede acelerar el número de mutaciones que se producen en el hongo. Consideró que el escenario planteado por la serie “The Last of Us” con un hongo adaptado al calor que se apodera de los humanos podría darse. Aunque no se produciría el cambio a “zombies”, aclaró.

En el caso de las enfermedades por hongos, no se transmiten directamente entre las personas. “Pero las esporas están en el aire. Respiramos esporas de hongos todo el tiempo y nuestro sistema inmune está preparado para combatirlas”, agregó.
Las esporas de hongos suelen ser más grandes que los virus. Por lo que su reserva actual de mascarillas contra el Covid probablemente sería suficiente para detenerlas. Eso, y el calor corporal podrían funcionar por ahora, según la investigadora.
“Las enfermedades fúngicas están aumentando, en gran parte debido al incremento del número de personas con sistemas inmunitarios debilitados o enfermedades subyacentes”, explicó Gusa. Pero al mismo tiempo, los hongos patógenos pueden estar adaptándose también a temperaturas más cálidas.
En colaboración con el laboratorio de la profesora Sue Jinks-Robertson, Gusa dirigió una investigación centrada en tres elementos móviles especialmente activos bajo estrés térmico en el hongo C. deneoformans. Pero en esa especie hay fácilmente otros 25 o más elementos que podrían movilizarse, dijo.

El equipo utilizó secuencias de ADN de “lectura larga” para detectar cambios que de otro modo habrían pasado desapercibidos. El análisis computacional les permitió cartografiar los transposones y ver cómo se habían desplazado. “Ahora tenemos herramientas mejoradas para ver estos movimientos que antes se escondían en nuestros puntos ciegos”, señaló.
El estrés térmico aceleró las mutaciones. Tras 800 generaciones de crecimiento en el laboratorio, la tasa de mutaciones de transposones fue cinco veces mayor en los hongos criados a temperatura corporal (37 grados centígrados) que en los cultivado a 30 grados.
Uno de los elementos transponibles, denominado “T1″, tenía tendencia a insertarse entre genes codificantes, lo que podía provocar cambios en la forma en que se controlan los genes. Un elemento denominado “Tcn12″ se insertaba a menudo en la secuencia de un gen, lo que podía alterar su función y provocar resistencia a los fármacos. Y un tercer tipo, el Cnl1, tendía a situarse cerca o en las secuencias teloméricas de los extremos de los cromosomas, un efecto que, según Gusa, aún no se conoce del todo.
La movilización de los elementos del ADN también parecía aumentar más en hongos que vivían en ratones que en cultivos de laboratorio. “Observamos indicios de que los tres elementos transponibles se movilizaban en el genoma del hongo a los diez días de infectar al ratón”, comentó Gusa. Los investigadores sospechan que los retos añadidos de sobrevivir en un animal con respuestas inmunitarias y otros factores de estrés pueden impulsar a los transposones a ser aún más activos.
“Se trata de un estudio fascinante, que muestra cómo el aumento de la temperatura global puede afectar a la evolución de los hongos en direcciones impredecibles”, sostuvo el doctor Arturo Casadevall, catedrático de Microbiología Molecular e Inmunología de la Universidad Johns Hopkins.

“A medida que el mundo se calienta, los elemento genéticos transponible o transposones en hongos del suelo como Cryptococcus neoformans podrían volverse más móviles y aumentar los cambios genómicos en formas que podrían aumentar la virulencia y la resistencia a los medicamentos”. Una razón más para preocuparse por el calentamiento global, según el científico que no participó en el estudio.
La siguiente fase de esta investigación consistirá en estudiar los patógenos de pacientes humanos que hayan sufrido una infección fúngica recidivante. “Sabemos que estas infecciones pueden persistir y luego reaparecer con posibles cambios genéticos”, adelantó.
“Es hora de ponerse serios con los hongos patógenos”, opinó Gusa. “Este tipo de cambios estimulados por el estrés pueden contribuir a la evolución de los rasgos patógenos de los hongos tanto en el ambiente como durante la infección. Pueden estar evolucionando más rápido de lo que esperábamos”, afirmó. La investigación contó con subsidios de los Institutos Nacionales de Salud de EE.UU.
Seguir leyendo:
Últimas Noticias
Detectaron un fenómeno inesperado en el crecimiento de agujeros negros supermasivos: investigan su origen
Un estudio establece que la ausencia de gas frío ha influido en la expansión de estos objetos, según comprobaciones realizadas con diferentes telescopios de rayos X

Astrónomos detectan dos planetas gigantes en formación alrededor de una estrella: el impactante fenómeno
Las observaciones realizadas por un consorcio internacional ofrecen pistas valiosas para desentrañar la evolución de sistemas similares al solar

La calidad del descanso no depende solo de cuántas horas dormimos: cómo los sueños pueden marcar la diferencia
Científicos de Italia analizaron la actividad cerebral y los relatos oníricos de 44 adultos tras más de mil despertares en laboratorio. Qué encontraron

La base lunar de la NASA: claves de la ciencia, la tecnología y la cooperación en el espacio
La agencia espacial estadounidense confirmó que busca instalar la primera base permanente antes de 2030. El plan, basado en el programa Artemis, cuenta con la participación de Japón, Italia y Canadá. La opinión de un experto a Infobae

Descubren nuevos beneficios de la dieta mediterránea para la salud del corazón y el cerebro
Un estudio científico analizó el impacto de este plan alimentario en el organismo. La relación entre su consumo y la presencia de proteínas celulares asociadas a un mejor funcionamiento cardiovascular y cerebral en personas mayores


